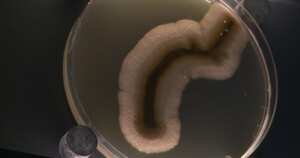
El primer zoológico de microbios

Mundo
Investigadores detectan por primera vez microplásticos en la sangre humana
Otro estudio había establecido ya una relación entre estas partículas en las heces humanas y la enfermedad inflamatoria intestinal.
Siga las noticias internacionales en Discover para conocer los hechos globales de hoy

Un estudio holandés dio cuenta, por primera vez pero con una muestra reducida, de la presencia de microplásticos en la sangre humana, descubrimiento que plantea interrogantes sobre una eventual penetración de estas partículas en los órganos.
Los autores del estudio, publicado el jueves en Environment International, analizaron muestras sanguíneas de 22 donantes anónimos, todos voluntarios en buena salud, y descubrieron microplásticos en 17 de ellos.
La mitad de las muestras contenía rastros de PET (politereftalato de etileno), uno de los plásticos más usados en el mundo, en particular en la fabricación de botellas y fibras de poliéster. Más de un tercio tenía poliestireno, usado entre otras cosas para el envasado de alimentos, y un cuarto polietileno.
“Por primera vez fuimos capaces de detectar y cuantificar” estos microplásticos en la sangre humana, declaró Dick Vethaak, ecotoxicólogo de la universidad libre de Ámsterdam.
“Esto prueba que tenemos plástico en nuestro cuerpo, y no deberíamos”, dijo a la AFP. Según el estudio, los microplásticos detectados pudieron penetrar en el cuerpo por múltiples vías: aéreas, acuáticas o por medio de la comida, o de los productos de higiene y cosmética.
“Es científicamente probable que partículas sanguíneas pueden ser llevadas hasta los órganos por medio del sistema sanguíneo”, anotaron sus autores.
Este estudio fue financiando por la Organización Holandesa para la Investigación y el Desarrollo en Salud y por Common Seas, una ONG medioambiental con sede en Reino Unido que busca reducir la contaminación con plástico.

Para Alice Horton, especialista en contaminantes antrópicos del centro británico de oceanografía, “pese a la pequeña muestra y las débiles concentraciones detectadas”, los métodos analíticos del estudio son “muy robustos”.
“Este estudio contribuye a demostrar que las partículas de plástico no solo se encuentran presentes en el medioambiente, sino también en nuestros cuerpos. Las consecuencias a largo plazo aún no son bien conocidas”, comentó al Science Media Centre.
Microplásticos en las heces humanas
Un estudio realizado por científicos de China dice que los microplásticos que pueden llegar a tener las heces humanas tienen vínculo con la enfermedad inflamatoria intestinal.
De acuerdo con información consignada por la Clínica de Mayo, esta afección tiene que ver con trastornos que se dan en el tracto digestivo y producen síntomas como diarrea, sangrado rectal, dolor abdominal, fatiga y pérdida de peso.
En consecuencia, el grupo de científicos explica que el plástico se ha convertido en un elemento de múltiples usos y, en la lucha de eliminarlos, aparecen micropartículas que se esparcen por todo el ecosistema. De allí que puedan llegar hasta el intestino del cuerpo humano.
Los microplásticos, como su nombre lo indica, son pequeñas partículas de plástico que están en cualquier lugar, incluso el organismo. Este último porque la composición de algunas bebidas y comidas los contienen.
El portal web de Ok Diario señala que, por ahora, la ciencia no ha podido descubrir del todo cómo los microplásticos impactan con severidad en la cotidianidad.
Sin embargo, ya existen investigaciones o estudios que están empezando a centrarse en esta vertiente, como la de los científicos asiáticos Zehua Yan, Ting zhang, Yafei Liu, Hongqiang Ren y Yan Zhang; el colectivo halló una relación entre las partículas de plástico y la enfermedad inflamatoria intestinal.
A través de un informe que se publicó en la revista Science, de la Asociación Americana, el colectivo determinó que hallaron altas concentraciones de microplásticos en pacientes diagnosticados con la enfermedad que se ubica en el estómago; en comparación con sujetos que no sufren de la enfermedad.
En ese sentido, indican que la correlación es fuerte y rotunda. No obstante, para llegar a mejores resultados se debe seguir ahondando el tema desde la ciencia y la salud. Conjuntamente, comparten que con el análisis de las heces se podría evaluar la exposición que tienen los humanos ante los microplásticos.
En ese orden de ideas, los investigadores asiáticos detectaron 15 tipos de microplásticos que aparecieron en las heces de personas diagnosticadas con la enfermedad inflamatoria intestinal. Entre los elementos que más sobresalen se encuentran el poli (tereftalato de etileno) y la poliamida, en forma de láminas y fibras.
Con todo esto, el colectivo estableció que la cantidad de microplásticos influye en la gravedad de la afección estomacal. Además, de acuerdo con un cuestionario, se explica que estos contaminantes se agregan en el cuerpo de los pacientes por medio de los envases o recipientes de plástico de agua potable, el polvo y los alimentos.
*Con información de la AFP.